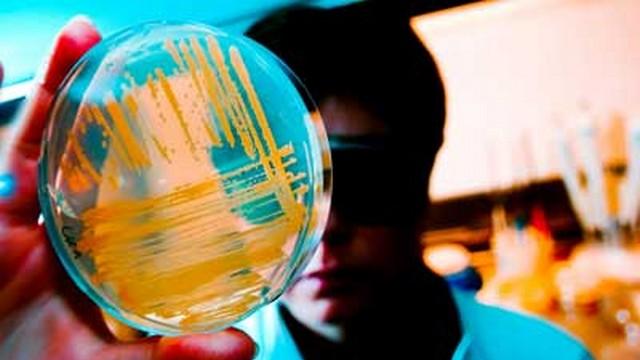
1 infricosator-bioweapon-11_tn

Ce face o arma puternica? Cuvantul puternic poate fi foarte subiectiv in acest caz. Cauzarea anihilarii masive este puternica, dar la fel este si incitarea fricii intr-o maniera prelungita si dureroasa. Orice poate distruge vieti si proprietati este puternic, dimpotriva, orice poate proteja vieti si proprietati de aceste 25 de arme cele mai puternice din istorie este, de asemenea, la fel de puternic. Nu opreste nicio tara sau institutie sa demonstreze lumii cat de puternice pot fi, fie prin distrugerea inamicului sau protejandu-si pe al lor.

O mitraliera autoalimentata care ar putea trage 600 de cartuse pe minut, ceea ce este echivalent cu puterea de foc a 30 de pusti cu suruburi contemporane. A fost asociat in cea mai mare parte cu cuceririle britanice si a fost folosit in mod celebru atunci cand 700 de soldati britanici au luptat cu 3.000 de razboinici cu doar patru tunuri Maxim in batalia de la Shangani.

Cu un diametru al mingii de 80 cm, acest super pistol a fost cea mai mare arma folosita in Austria secolului al XV-lea. Muzeul Heeresgeschichtliches din Viena gazduieste astazi aceasta bombarda monstruoasa.

Cel mai mare tun din lume are vreodata un calibru de 975 mm. Creata de Joseph Paixhans, aceasta arma monstruoasa si-a jucat notorietatea in timpul Asediului Anversului din 1832.

Acest tun gravat este cel mai mare obuzier realizat vreodata. Cantareste 38 de tone si are 5,34 metri lungime. Construita in 1586, aceasta arma masiva este acum expusa la Kremlinul din Moscova, Rusia.

Primul vehicul de razboi numit tanc putea transporta 5 mitraliere si 8 soldati. Mark I a avut mai multe upgrade-uri numerotate de la II la X, dar toate aveau aceeasi asemanare cu „Mama” lor. Acest tanc masiv si variantele sale au fost folosite de mai multe tari de-a lungul Primului Razboi Mondial.

Aceasta masina rea creata de Rheinmetall pentru masina de razboi nazista a fost cea mai mare arma autopropulsata care a fost folosita in atacurile reale din timpul celui de-al Doilea Razboi Mondial.
Heavy Gustav si Dora

Aceste doua tunuri uriase din perioada celui de-al Doilea Razboi Mondial german de asediu feroviar de 80 cm sunt cele mai mari arme de calibru din istorie folosite in lupta reala, iar obuzele sale sunt cele mai grele dintre toate munitiile vreodata.

Ruchnoy Protivotankovyy Granatomyot sau lansator de grenade antitanc de mana sau pur si simplu RPG-ul este cea mai folosita arma anti-blindura din lume. Folosit atat de armate, cat si de grupuri de insurgenti, RPG este chiar campul de lupta impotriva adversarilor cu artilerie mai grea.

Aceasta bomba gravitationala este cel mai puternic focos nuclear al Statelor Unite, dar a fost deja retrasa in 1957. Singurele 2 bombardiere care au transportat-o au fost B-52 Stratofortress si B-47 Stratojet.

Cu o viteza maxima de Mach 3, aceasta racheta de croaziera supersonica supersonica rusa de croaziera ingreuneaza inamicii sa contracareze atacul. Nu numai ca, din cauza secretului armelor militare active, se stie putin despre fundalul sau, cu exceptia unor masuratori, viteza calculata si alte cateva informatii foarte elementare.

In afara de faptul ca vitezele sale inregistrate sunt intre Mach 2,9 si uimitor Mach 5,7, ceea ce o face mult mai rapida decat articolul anterior de pe aceasta lista, aceasta racheta de croaziera supersonica anti-nava rusa poate, de asemenea, scufunda eficient un transportator american. Asta e puternic.

O clasa de rachete iraniene cu raza lunga de actiune care ar putea atinge pana la 5.000 km, actualizarile de rachete Shahab sunt invaluite in secret, dar se presupune ca ar fi folosite in timpul unei posibile invazii a Israelului.
Racheta Agni este o familie de rachete balistice cu raza medie pana la intercontinentala dezvoltata de India, numita dupa unul dintre cele cinci elemente ale naturii.

Racheta Agni este o familie de rachete balistice cu raza medie pana la intercontinentala dezvoltata de India, numita dupa unul dintre cele cinci elemente ale naturii.
Fat Man si Little Boy

Cu totii suntem familiarizati cu bombardamentele de la Nagasaki si Hiroshima care au schimbat cursul istoriei in timpul ultimului razboi mondial. Numiti dupa personajele de film, aceste doua bombe nucleare infame au oferit omenirii o amintire socanta a ceea ce poate face razboiul unei natiuni si generatiei sale viitoare.

Cele 9 megatone de TNT din B53 si-au revendicat drept cel mai puternic focos de pana acum. Este una dintre ultimele bombe termonucleare cu randament foarte mare din serviciul SUA, dar nu mai este folosita activ.
MOAB/GBU-43/B Ordonanta masiva

In timpul dezvoltarii sale, Mama tuturor bombelor sau Ordonanta Massice GBU-43/B, numita oficial, a fost considerata cea mai puternica arma nenucleara conceputa vreodata. Testata pe 11 martie 2003, explozia sa poate distruge 9 blocuri cu o raza de 137,61 m. Se pare ca a fost dezvoltata o versiune mai mare de 13 tone.
FOAB sau bomba termobara de aviatie de putere crescuta (ATBIP)

Poreclit „Parintele tuturor bombelor” (FOAB), aceasta este o arma termobarica produsa din Rusia, livrata cu aer/activata pe sol. In descrierea puterii distructive a bombei, seful adjunct al Statului Major rus, Alexander Rukshin, a spus ca „tot ceea ce este viu doar se evapora”.
Tarul Bomba

Iti amintesti acele explozii enorme de nori de ciuperci din cartile de istorie? Ei bine, acestea au fost cauzate de acesti tipi. Bomba tarului avea o masa de 27 de tone si avea sa creeze o minge de foc cu o raza de 3,5 kilometri.
Portavion clasa Nimitz

Cu reactoare nucleare gemene care nu au nevoie de realimentare timp de 23 de ani si golfuri care sunt capabile sa tina pana la 130 F/A-18 Hornet, doar aspectul acestui transportator in orice regiune este suficient pentru a influenta politica globala.
Airborne Laser/Boeing YAL-1

Sistemul de arme Boeing YAL-1 Airborne Laser Testbed, (fostul Airborne Laser) este un laser chimic cu oxigen iod (COIL) de clasa megawati montat in interiorul unui Boeing 747-400F modificat. Este conceput in primul rand ca un sistem de aparare antiracheta pentru a distruge rachetele balistice tactice (TBM), dar finantarea programului a fost redusa in 2010.
Predatorul si Predatorul B (alias The Reaper)

Folosite de Statele Unite, Royal Air Force si Fortele Aeriene Italiene, aceste drone devin din ce in ce mai comune atat pentru operatiunile de lupta, cat si pentru cele de recunoastere.
Trident II D5 SLBM

Lansata dintr-un submarin, aceasta racheta contine opt focoase termonucleare. Este o veste proasta pentru oricine, chiar si de la distanta, aproape de tinta.
R-36 ICBM

Diferenta dintre intrarea anterioara si aceasta racheta ruseasca este numarul de focoase pe care le poate transporta si faptul ca este lansata in mod normal de pe uscat. Cu sarcina sa utila masiva, acest ICBM nu ar avea prea multe probleme sa initieze un holocaust nuclear.
Cadavre

Bombele nucleare si laserele sunt infricosatoare si puternice, fara indoiala. Dar, dupa cum se spune, exista mai multe modalitati de a jupui o pisica si, daca te indrepti spre o distrugere lenta si devastatoare mental, lansarea uneori a trupurilor bolnave si ciuruite ale prizonierilor pe care le-ai executat inapoi peste zidurile orasului este cel mai sadic mod de a sa decimeze o populatie.
Virusii himere
Asa cum tocmai am spus, a putea distruge un intreg oras in mai putin de o secunda prin apasarea unui buton este o modalitate de a masura puterea distructiva, dar a putea decima selectiv si lent o populatie cu boala si infectie este atat de neconventional de brutal incat trebuie sa fie in fruntea listei.






















